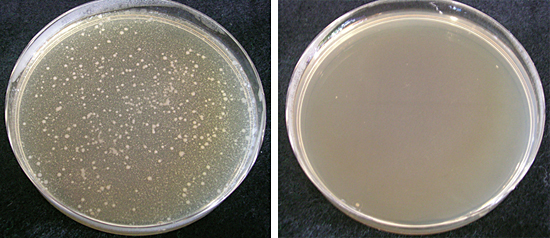
洗濯後の衣類の雑菌増殖比較(18時間後)

洗濯物のニオイを防ぐ! 東芝「AW-90SVM」の「パワーアップAg+抗菌水」で徹底除菌
洗濯機といえば、最近はドラム式が注目されているが、店頭のタテ型洗濯機の人気には、まだ根強いものがある。ドラム式に比べてコンパクトで、使い慣れているから安心といった声が多いのだ。そんな市場に、7月10日、東芝「ZABOON」シリーズの最新機種「AW-90SVM」が加わった。部屋干しのニオイを防ぎ、洗濯槽を丸ごと掃除する「パワーアップAg+抗菌水」がウリのこのモデルを紹介しよう。
部屋干しをすると、洗濯物のニオイが気になってくる。部屋干し用の消臭効果や香りつけの効果がある洗剤や柔軟剤を使う、洗い終わったらすぐに干す、エアコンの除湿機能を使って手早く乾かすなど、いろいろな対策をしても、ニオイが気になることがある。
そもそもこのニオイは、洗濯で落ちなかった汚れを雑菌がエサにして繁殖することで発生する。これをなくすには、洗濯物の汚れをきちんと落とすことはもちろん、まず洗濯槽も清潔に保つ必要がある。つまり、「きちんと汚れが落ちる、キレイな洗濯機」で洗濯すれば、部屋干しのニオイも抑えられるわけだ。
東芝のタテ型洗濯機「ZABOON」シリーズは、抗菌効果のある「Ag+抗菌水」で洗濯物を洗い、菌の発生を抑えることができるスグレモノ。最新モデルの「AW-90SVM」は、抗菌効果がパワーアップした「パワーアップAg+抗菌水」で洗濯する。
銀イオンの抗菌成分を含む「Ag+抗菌ビーズ」を洗濯時の水が通る「Ag+抗菌水ユニット」に装備し、水に銀イオンの成分を溶かして「Ag+抗菌水」をつくる。「AW-90SVM」は、この「Ag+抗菌ビーズ」の量を従来モデルより20%増量し、抗菌効果を高めた。洗いからすすぎまで「パワーアップAg+抗菌水」を使うことで、衣類の雑菌増殖をしっかり抑える。水道水だけでなく、ふろの残り湯もこの「Ag+抗菌水ユニット」を通るので、抗菌の効果を発揮する。「Ag+抗菌水ユニット」は約10年間交換不要で、「Ag+抗菌ビーズ」の補充の心配もない。
「パワーアップAg+抗菌水」は、衣類だけではなく、洗濯槽の洗浄にも効果がある。「AW-90SVM」は、脱水時に洗濯槽の裏側を「パワーアップAg+抗菌水」で自動的に洗う仕組みで、追加の水や時間をかけずに洗浄する。部屋干しのニオイを防ぐには、洗濯槽も清潔に保つ事が大切なので、この仕組みはニオイ防止に効果的だ。さらに、洗濯槽用の洗剤や漂白剤を使って清掃する手間も減る。
「AW-90SVM」は、「パワーアップAg+抗菌水」で衣類や洗濯槽を洗うだけではなく、「ピコイオン除菌」を使った黒カビ予防も行うことができる。「ピコイオン」とはナノの1000分の1の大きさで、雑菌などを包み込んで菌の活動を抑制する効果があるイオンだ。
この「ピコイオン」を洗濯後の洗濯槽に吹きかけることで黒カビが発生しにくくなり、清潔な洗濯槽が持続する。また、革靴や枕など、洗えないものを洗濯槽に入れてこの「ピコイオン除菌」で除菌・消臭することができる。
例えば、スーツなら1着1時間程度で除菌・消臭ができる。仕事帰りに寄った焼肉屋でついてしまったニオイなどを、その日のうちに消臭できるわけだ。
このほか、よく手を触れるふろ水ホースの先端や糸くずフィルターにも抗菌加工を施し、清潔を保つよう気を配っている。これだけ徹底していれば、洗濯機の雑菌が洗濯物につく心配をする必要はなさそうだ。
「ZABOON」シリーズは、もともと低騒音で定評があったが、「AW-90SVM」は独自の「S-DDモーター」と「DSPコントロール」で駆動音をさらに抑えている。
一般的な洗濯機は、洗濯槽と洗濯槽を回すモーターをギアやベルトでつないでいるものが多い。ギアやベルトを介して運転するので、駆動音がしてしまう。「AW-90SVM」は、洗濯槽とモーターを直結し、ベルトを省くことで駆動音を抑えている。さらに、洗濯物の量や状態をセンサで検知して洗濯槽の回転を制御する「DSPコントロール」で、効率よく洗濯槽を回すことで振動を抑える。
実際、「AW-90SVM」の運転音は、洗いのときはささやき声程度の約28dB、脱水のときは静かな公園程度の約37dBと、タテ型洗濯機でトップクラスの低騒音を実現している。洗濯機の運転音が大きいと集合住宅ではトラブルの元になりがち。低騒音の洗濯機で夜や早朝に洗濯できれば、時間も有効活用できる。「東芝の洗濯機は静か」というイメージ通りのモデルだ。
「ZABOON」シリーズのもう一つの特徴が、洗濯時間が短いこと。「AW-90SVM」は、5年前のモデルより18分も短い約35分で洗濯ができる。もちろん、洗濯時間を短縮しても洗浄力は落としていない。段差の異なる2方向から水を注ぐ「段違いメガシャワー」で繊維の奥の汚れを押し出し、さらに底面の回転羽根「ザブーンパル」で力強い水流をつくり、洗いムラなく衣類を洗浄する。タテ型洗濯機を選ぶ理由の一つに、洗浄力を挙げる家庭も少なくないだけに、このパワーは好印象だ。
デリケートな素材の衣類の洗濯にも、しっかり対応している。付属の「おしゃれ着トレー」を底面に設置すれば回転羽根に衣類が直接当たらないので、布傷みを抑えることができる。汚れは「段違いメガシャワー」の押し洗い効果でしっかり落とすので、ウールのセーターや学生服、スカートなど、手洗いやドライが指定されているおしゃれ着をダメージを抑えながらしっかり洗うことができる。
さらに「AW-90SVM」は、乾燥機能を備えている。独自の「そのまま乾燥コース」は、回転羽根でかくはんしないで乾燥させるので、型崩れの気になる衣類や乾きにくい上履きなどの乾燥にも使えて、いざというときに便利だ。
ここまでみてきた通り、「AW-90SVM」は洗濯、除菌、乾燥まで多くの機能をもっている。ここまで高機能だと、上手な使いこなしがカギになってくるが、その点も心配はいらない。「AW-90SVM」は、タテ型洗濯機には珍しく大きめの液晶パネルと、クルクル回して操作する「フラットダイヤル」を備えている。
さらに時計機能つきで、予約するときは液晶パネルと「フラットダイヤル」を使って、目覚まし時計と同じように「仕上がり時間」を時計でセットできる。これまでの洗濯機は「~時間後」という仕上がり時間のセットが一般的なので、この設定のしやすさには驚いた。
衣類も洗濯槽も自動で清潔にし、部屋干しのニオイを防ぐ「パワーアップAg+抗菌水」「ピコイオン除菌」は本当にありがたい機能だ。
そして、高い低騒音性で寝ている間に洗濯できるから、朝方仕上がるように予約して出勤前に干すこともできる。おしゃれ着も安心してしっかり洗えるので、クリーニング代も節約できそうだ。
洗濯9kgのモデルながら、奥行き内寸510mm以上の防水パンに設置できるコンパクトなモデルなので、設置場所は狭いが大容量のものがほしいという家庭に迷わずおすすめできる。パワフルな洗浄とおしゃれ着洗いの機能をうまく使い分けて、長く使いたいモデルだ。(フリーライター・西村敦子)

7月10日発売の「ZABOON AW-90SVM」、カラーは左からシェルホワイト、ホワイトシルバー
「パワーアップAg+抗菌水」で部屋干しのニオイを防ぐ
部屋干しをすると、洗濯物のニオイが気になってくる。部屋干し用の消臭効果や香りつけの効果がある洗剤や柔軟剤を使う、洗い終わったらすぐに干す、エアコンの除湿機能を使って手早く乾かすなど、いろいろな対策をしても、ニオイが気になることがある。
そもそもこのニオイは、洗濯で落ちなかった汚れを雑菌がエサにして繁殖することで発生する。これをなくすには、洗濯物の汚れをきちんと落とすことはもちろん、まず洗濯槽も清潔に保つ必要がある。つまり、「きちんと汚れが落ちる、キレイな洗濯機」で洗濯すれば、部屋干しのニオイも抑えられるわけだ。
東芝のタテ型洗濯機「ZABOON」シリーズは、抗菌効果のある「Ag+抗菌水」で洗濯物を洗い、菌の発生を抑えることができるスグレモノ。最新モデルの「AW-90SVM」は、抗菌効果がパワーアップした「パワーアップAg+抗菌水」で洗濯する。
銀イオンの抗菌成分を含む「Ag+抗菌ビーズ」を洗濯時の水が通る「Ag+抗菌水ユニット」に装備し、水に銀イオンの成分を溶かして「Ag+抗菌水」をつくる。「AW-90SVM」は、この「Ag+抗菌ビーズ」の量を従来モデルより20%増量し、抗菌効果を高めた。洗いからすすぎまで「パワーアップAg+抗菌水」を使うことで、衣類の雑菌増殖をしっかり抑える。水道水だけでなく、ふろの残り湯もこの「Ag+抗菌水ユニット」を通るので、抗菌の効果を発揮する。「Ag+抗菌水ユニット」は約10年間交換不要で、「Ag+抗菌ビーズ」の補充の心配もない。

「Ag+抗菌水」をつくる「Ag+抗菌水ユニット」(左)と「Ag+抗菌ビーズ」(右)
「パワーアップAg+抗菌水」は、衣類だけではなく、洗濯槽の洗浄にも効果がある。「AW-90SVM」は、脱水時に洗濯槽の裏側を「パワーアップAg+抗菌水」で自動的に洗う仕組みで、追加の水や時間をかけずに洗浄する。部屋干しのニオイを防ぐには、洗濯槽も清潔に保つ事が大切なので、この仕組みはニオイ防止に効果的だ。さらに、洗濯槽用の洗剤や漂白剤を使って清掃する手間も減る。
洗濯後の衣類の雑菌増殖比較(18時間後)。左が水道水で洗濯した場合、右が「Ag+抗菌水」で洗濯した場合
「パワーアップAg+抗菌水」と「ピコイオン」でダブル除菌
「AW-90SVM」は、「パワーアップAg+抗菌水」で衣類や洗濯槽を洗うだけではなく、「ピコイオン除菌」を使った黒カビ予防も行うことができる。「ピコイオン」とはナノの1000分の1の大きさで、雑菌などを包み込んで菌の活動を抑制する効果があるイオンだ。
この「ピコイオン」を洗濯後の洗濯槽に吹きかけることで黒カビが発生しにくくなり、清潔な洗濯槽が持続する。また、革靴や枕など、洗えないものを洗濯槽に入れてこの「ピコイオン除菌」で除菌・消臭することができる。

ピコイオン除菌のイメージ
例えば、スーツなら1着1時間程度で除菌・消臭ができる。仕事帰りに寄った焼肉屋でついてしまったニオイなどを、その日のうちに消臭できるわけだ。
このほか、よく手を触れるふろ水ホースの先端や糸くずフィルターにも抗菌加工を施し、清潔を保つよう気を配っている。これだけ徹底していれば、洗濯機の雑菌が洗濯物につく心配をする必要はなさそうだ。

ふろ水ホース(左)や糸くずフィルター(右)にも抗菌加工
洗いも脱水も低騒音 平日の夜でも安心して洗濯できる
「ZABOON」シリーズは、もともと低騒音で定評があったが、「AW-90SVM」は独自の「S-DDモーター」と「DSPコントロール」で駆動音をさらに抑えている。
一般的な洗濯機は、洗濯槽と洗濯槽を回すモーターをギアやベルトでつないでいるものが多い。ギアやベルトを介して運転するので、駆動音がしてしまう。「AW-90SVM」は、洗濯槽とモーターを直結し、ベルトを省くことで駆動音を抑えている。さらに、洗濯物の量や状態をセンサで検知して洗濯槽の回転を制御する「DSPコントロール」で、効率よく洗濯槽を回すことで振動を抑える。

「AW-90SVM」のモーター(左)と2012年度機種「AW-70GL」のモーター(右)。
「AW-70GL」はベルトを介して運転するので駆動音がしてしまう
「AW-70GL」はベルトを介して運転するので駆動音がしてしまう
実際、「AW-90SVM」の運転音は、洗いのときはささやき声程度の約28dB、脱水のときは静かな公園程度の約37dBと、タテ型洗濯機でトップクラスの低騒音を実現している。洗濯機の運転音が大きいと集合住宅ではトラブルの元になりがち。低騒音の洗濯機で夜や早朝に洗濯できれば、時間も有効活用できる。「東芝の洗濯機は静か」というイメージ通りのモデルだ。
「快速ザブーン洗浄」で時間も水も節約
「ZABOON」シリーズのもう一つの特徴が、洗濯時間が短いこと。「AW-90SVM」は、5年前のモデルより18分も短い約35分で洗濯ができる。もちろん、洗濯時間を短縮しても洗浄力は落としていない。段差の異なる2方向から水を注ぐ「段違いメガシャワー」で繊維の奥の汚れを押し出し、さらに底面の回転羽根「ザブーンパル」で力強い水流をつくり、洗いムラなく衣類を洗浄する。タテ型洗濯機を選ぶ理由の一つに、洗浄力を挙げる家庭も少なくないだけに、このパワーは好印象だ。

水の放出口を高さを変えて設置。少ない水でもムラなく洗うことができる
デリケートな素材の衣類の洗濯にも、しっかり対応している。付属の「おしゃれ着トレー」を底面に設置すれば回転羽根に衣類が直接当たらないので、布傷みを抑えることができる。汚れは「段違いメガシャワー」の押し洗い効果でしっかり落とすので、ウールのセーターや学生服、スカートなど、手洗いやドライが指定されているおしゃれ着をダメージを抑えながらしっかり洗うことができる。

デリケートな衣類を「おしゃれ着トレー」に乗せてしっかり、やさしく洗浄
さらに「AW-90SVM」は、乾燥機能を備えている。独自の「そのまま乾燥コース」は、回転羽根でかくはんしないで乾燥させるので、型崩れの気になる衣類や乾きにくい上履きなどの乾燥にも使えて、いざというときに便利だ。

乾きにくい上履きや帽子などの乾燥にも使える
ここまでみてきた通り、「AW-90SVM」は洗濯、除菌、乾燥まで多くの機能をもっている。ここまで高機能だと、上手な使いこなしがカギになってくるが、その点も心配はいらない。「AW-90SVM」は、タテ型洗濯機には珍しく大きめの液晶パネルと、クルクル回して操作する「フラットダイヤル」を備えている。
さらに時計機能つきで、予約するときは液晶パネルと「フラットダイヤル」を使って、目覚まし時計と同じように「仕上がり時間」を時計でセットできる。これまでの洗濯機は「~時間後」という仕上がり時間のセットが一般的なので、この設定のしやすさには驚いた。

「フラットダイヤル」をクルクル回す簡単設定
「パワーアップAg+抗菌水」の効果の高さと低騒音に期待したい
衣類も洗濯槽も自動で清潔にし、部屋干しのニオイを防ぐ「パワーアップAg+抗菌水」「ピコイオン除菌」は本当にありがたい機能だ。
そして、高い低騒音性で寝ている間に洗濯できるから、朝方仕上がるように予約して出勤前に干すこともできる。おしゃれ着も安心してしっかり洗えるので、クリーニング代も節約できそうだ。
洗濯9kgのモデルながら、奥行き内寸510mm以上の防水パンに設置できるコンパクトなモデルなので、設置場所は狭いが大容量のものがほしいという家庭に迷わずおすすめできる。パワフルな洗浄とおしゃれ着洗いの機能をうまく使い分けて、長く使いたいモデルだ。(フリーライター・西村敦子)





